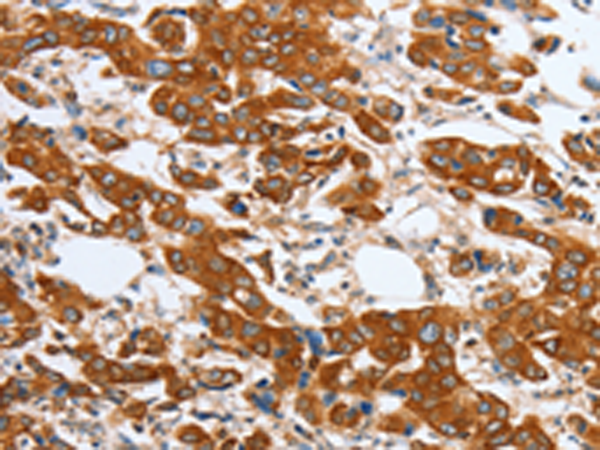
一抗

中文名稱: 兔抗MAPT多克隆抗體
英文名稱: Anti-MAPT rabbit polyclonal antibody
別 名: TAU; MSTD; PPND; DDPAC; MAPTL; MTBT1; MTBT2; FTDP-17
抗 原: MAPT
儲 存: 冷凍(-20℃)
宿 主: Rabbit
相關(guān)類別: 一抗
反應(yīng)種屬: Human, Mouse, Rat
標(biāo) 記 物: Unconjugate
克隆類型: rabbit polyclonal
技術(shù)規(guī)格
|
Background: |
This gene encodes the microtubule-associated protein tau (MAPT) whose transcript undergoes complex, regulated alternative splicing, giving rise to several mRNA species. MAPT transcripts are differentially expressed in the nervous system, depending on stage of neuronal maturation and neuron type. MAPT gene mutations have been associated with several neurodegenerative disorders such as Alzheimer's disease, Pick's disease, frontotemporal dementia, cortico-basal degeneration and progressive supranuclear palsy. |
|
Applications: |
ELISA, IHC |
|
Name of antibody: |
MAPT |
|
Immunogen: |
Fusion protein of human MAPT |
|
Full name: |
microtubule-associated protein tau |
|
Synonyms: |
TAU; MSTD; PPND; DDPAC; MAPTL; MTBT1; MTBT2; FTDP-17 |
|
SwissProt: |
P10636 |
|
ELISA Recommended dilution: |
2000-5000 |
|
IHC positive control: |
Human breast cancer |
|
IHC Recommend dilution: |
25-100 |

 購物車
購物車 幫助
幫助
 021-54845833/15800441009
021-54845833/15800441009